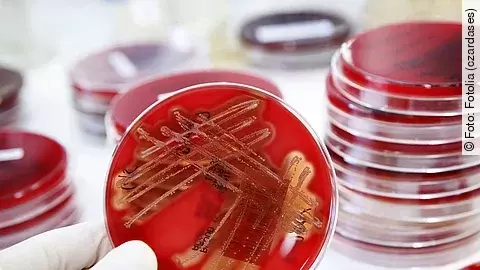
Bakterien

Der letzte der drei betroffenen Patienten sei in der vergangenen Woche aus der Quarantäne entlassen worden, sagte eine Mitarbeiterin des Klinikums am Dienstag. Die Intensivstation sei desinfiziert worden und stehe seit Samstag nach Absprache mit dem Gesundheitsamt wieder zur Verfügung. Zuvor hatten „Südkurier“ und „Schwäbische Zeitung“ berichtet. Anfang August war es in der Klinik zu einer unerwarteten Häufung von Kolonisationen mit sogenannten Vancomycin-resistenten Enterokokken (VRE) gekommen. Daraufhin musste die Intensivstation für die Desinfektion teilweise gesperrt werden.

Derzeit sind noch keine Kommentare vorhanden. Schreiben Sie den ersten Kommentar!
Jetzt einloggen